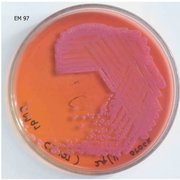

Learn Mcb
Study Mcb using smart web & mobile flashcards created by top students, teachers, and professors. Prep for a quiz or learn for fun!
Brainscape Certified flashcards
(0)
Decks
Flashcards
Learners
User Generated flashcards
(30)
Decks
Flashcards
Learners
-
MCB 11 - 2nd Lec Exam!
MCB 11 - 2nd Lec Exam!
By: iyaaaa chriszele
Classification of Microorganisms, The Prokaryotes2Decks82Flashcards1Learner -
MCB 10 - Intro to Human Heredity
MCB 10 - Intro to Human Heredity
By: Ryan Marquez
Exam 11Decks43Flashcards1Learner -
Éthique en Microbiologie et Immunologie (MCB-1040)
Éthique en Microbiologie et Immunologie (MCB-1040)
By: Marc-andré Limoges
Cours 1 - Bioéthique en microbiologie et immunologie, Cours 2 - L'éthique et l'animal de laboratoire, Cours 3 - Éthique de l'environnement3Decks42Flashcards2Learners -
MCB 32 Introduction to Human Physiology
MCB 32 Introduction to Human Physiology
By: Maggy Li
Introduction to Physiology (Chapter 1), Cell Membrane (Chapter 4)2Decks58Flashcards2Learners -
MCB
MCB
By: Jasmin Joseph
MCB Exam 32Decks48Flashcards1Learner -
Cell Biology (MCB 2210)
Cell Biology (MCB 2210)
By: Molly Zgoda
Block 4 Lectures, Problem Set 72Decks230Flashcards1Learner -
MCB
MCB
By: Patricia Ablanedo Morales
Chapter 17: Cell cycle, Chapter 18: Cell death and renewal2Decks34Flashcards1Learner -
MCB 325
MCB 325
By: alex shamir
Week 1, Week 2, Week 33Decks62Flashcards1Learner -
MCB
MCB
By: Kendal McCarthy
MCB deck 11Decks83Flashcards1Learner -
MCB 2050 Part 2
MCB 2050 Part 2
By: Kyla Hrycusko
The Nucleus, Nuclear Transport, Endomembrane System ...4Decks62Flashcards1Learner -
MCB - Topic 2
MCB - Topic 2
By: Ashleigh Hutt
Genes and Genomes, Chromosomes and Replication, Gene Regulation ...5Decks74Flashcards1Learner -
MCB
MCB
By: zhuoer li
Biomolecules1Decks76Flashcards1Learner -
MCB 10
MCB 10
By: Yonni Michovska
Lecture 1, Chapter 12Decks42Flashcards1Learner -
MCB 247
MCB 247
By: Ella Jimenez
Endocrine System1Decks118Flashcards1Learner -
MCB 100
MCB 100
By: Thomas Stirnimann
Introduction, Historique, Structure et morphologie bactérienne ...5Decks34Flashcards1Learner -
My MCB-1908
My MCB-1908
By: hadi nasrallah
Historique, Microscopes, Morphologie Bactéries3Decks168Flashcards1Learner -
Disease MCB
Disease MCB
By: Dzenana Cabaravdic
Disease MCB1Decks105Flashcards1Learner -
MCB Proteins
MCB Proteins
By: Dzenana Cabaravdic
MCB Block 31Decks118Flashcards1Learner -
molecular and cellular biomedicine (MCB)
molecular and cellular biomedicine (MCB)
By: Angie Stef
module 1.1, module 1.2, module 1.3 ...4Decks179Flashcards1Learner -
MCB I
MCB I
By: Nick Weber
Block11Decks85Flashcards1Learner -
MCB
MCB
By: Messi Nancy
lecture 11Decks44Flashcards1Learner -
MCB 2
MCB 2
By: Tyler Coombes
Cancer1Decks91Flashcards1Learner -
MCB 2
MCB 2
By: Brie Gossman
BLOCK 21Decks98Flashcards1Learner -
mcb
mcb
By: elene X
Pseudomonas, Acinetobacter, Burkholderia, and Stenotrophomonas1Decks20Flashcards1Learner -
MCB
MCB
By: Jessica Handreck
Topic 51Decks35Flashcards1Learner -
MCB 162 Human Genome & Genetic Variation
MCB 162 Human Genome & Genetic Variation
By: Waverly C
Lecture 11, Lecture 12, Lecture 15 ...5Decks69Flashcards1Learner -
MCB 2050
MCB 2050
By: Audrey Barta
Nuclear Import/Export1Decks69Flashcards1Learner -
MCB 10
MCB 10
By: Ayush Shrestha
Unit 11Decks63Flashcards1Learner -
MCB 102: Survey Of Biochemistry
MCB 102: Survey Of Biochemistry
By: Kevin Dichoso
Amino Acid Structures, Glycolysis Naming Enzymes & Structures, Glycolysis WTF DOES THIS ENZYME DO?!3Decks40Flashcards1Learner -
MCB 2610

MCB 2610
By: Haneen Fiazuddin
Exam 3, Squid Guest Lecture2Decks26Flashcards1Learner



